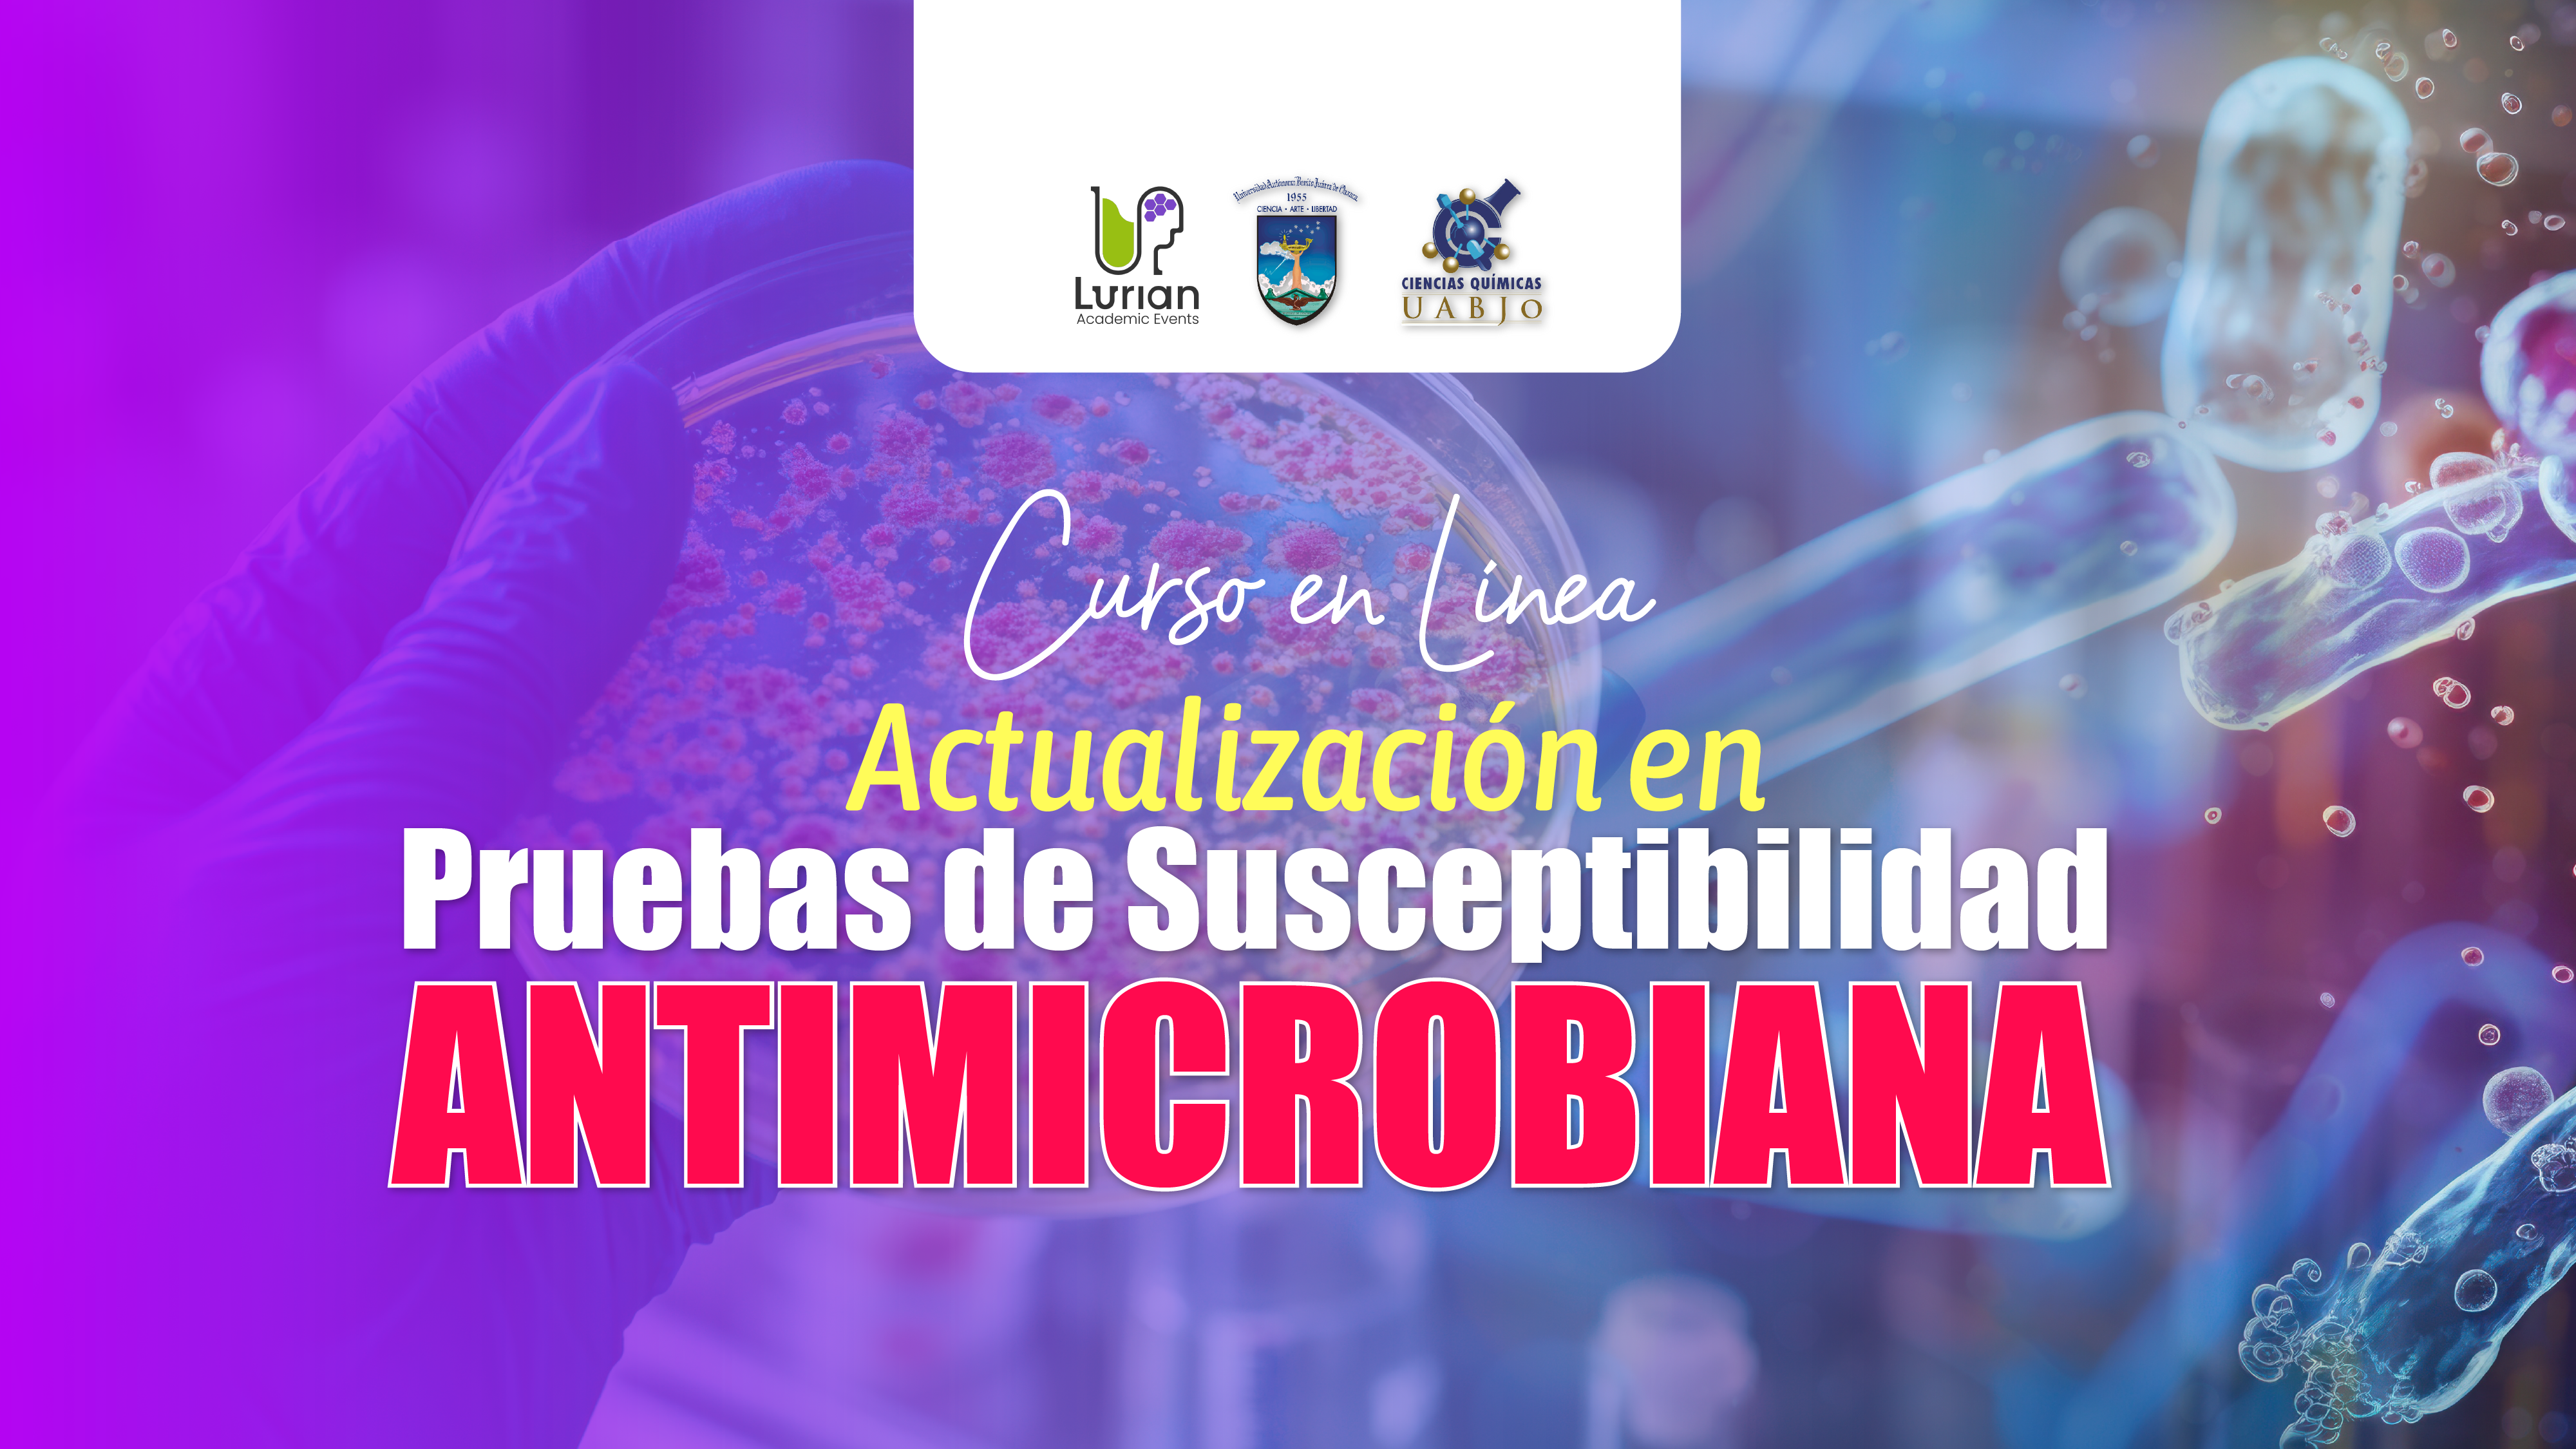
Curso en Línea Actualización en Pruebas de Susceptibilidad Antimicrobiana 2025 1.2

Lurian Academic
Lurian Academic
10 Cursos


Bacteriología y Microbiología
Curso en Línea Identificación y Clasificación de Cocos Gram Positivos Staphylococcus – Streptococcus – Enterococcus
Bacteriología y Microbiología
Curso en Línea Actualización en Pruebas de Susceptibilidad Antimicrobiana 2025 1.2

Bacteriología y Microbiología
Curso en Línea Control de Calidad en Bacteriología "Buenas Prácticas en el Proceso Diagnóstico"

Bacteriología y Microbiología
Curso en Línea Control de Calidad en Bacteriología "Buenas Prácticas en el Proceso Diagnóstico" 2

Bacteriología y Microbiología
Curso en Línea Tracto Gastrointestinal y Microbiota: Bases, Funciones E Interacciones Sistémicas 2025

Bacteriología y Microbiología
Diplomado en Línea de Líquidos Corporales “DEL ANÁLISIS AL DIAGNÓSTICO” 2025



